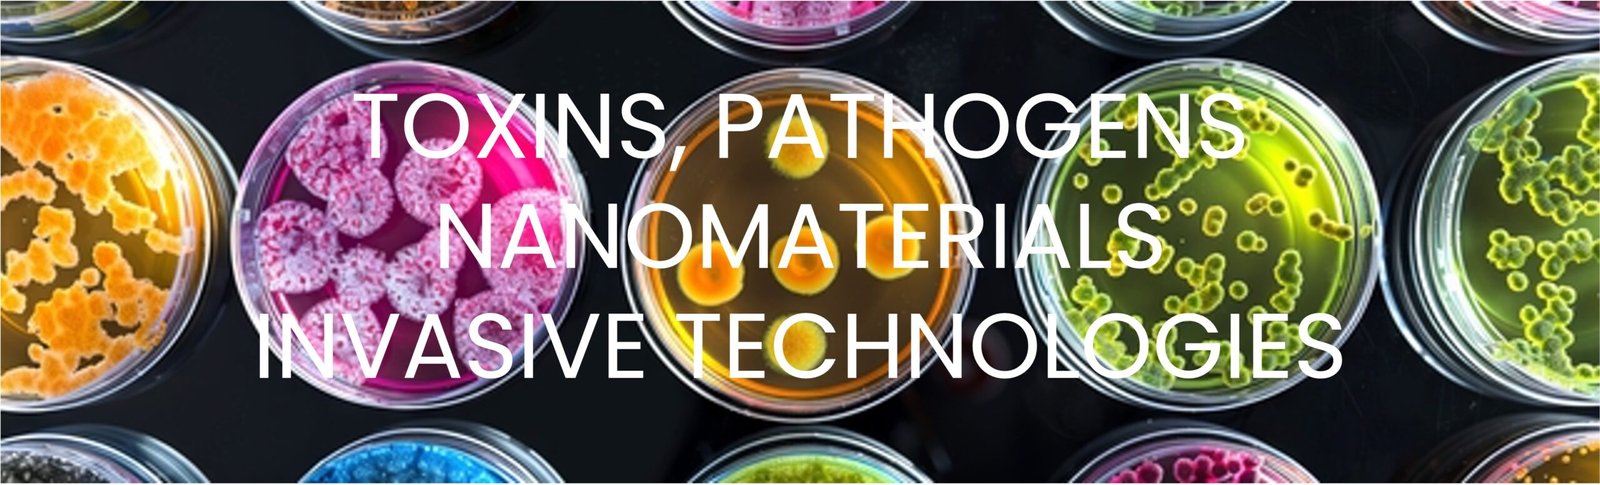
Toxins & Pathogens

The human body is under siege from four distinct categories of intervention: chemical toxins that poison and accumulate, engineered pathogens that reprogram cellular function, advanced nanomaterials that form synthetic networks inside tissue, and invasive technologies that manipulate consciousness itself. Each operates through different mechanisms. Each targets different systems. But together, they form a comprehensive biological takeover—transforming the body from a self-regulating organism into a hybrid platform that responds to external signals, harbors foreign materials, and operates under compromised programming
Toxins: Silent Chemical Warfare
PFAS (Per- and Polyfluoroalkyl Substances) began with DuPont and Teflon in the 1940s—a “miracle” coating that made pans non-stick and fabrics water-resistant. What started as a convenience has become a global contamination crisis. There are now over 7,000,000 variants of PFAS chemicals in circulation, and they are called “forever chemicals” because they do not break down in the environment or the human body. Ever.
PFAS are found in non-stick cookware (Teflon pans, air fryers), stain-resistant furniture and carpets, waterproof clothing and outdoor gear, food packaging (fast food wrappers, microwave popcorn bags, pizza boxes), cosmetics (foundation, mascara, lipstick), dental floss, cleaning products, and tap water across nearly every municipality in the developed world.
These chemicals accumulate in blood, liver, and kidneys, disrupting thyroid function, suppressing immune response, causing reproductive harm, and significantly increasing cancer risk. The EPA has acknowledged there is no safe level of PFAS exposure, yet they remain in thousands of consumer products. You are surrounded by them. You are consuming them daily. And they are rebuilding your biology from the inside out.
Phthalates: Endocrine Destroyers
Phthalates are plasticizers—chemicals added to make plastic soft and flexible. They are found in nearly every plastic product you touch, vinyl flooring, shower curtains, food containers, cling wrap, children’s toys, personal care products (shampoo, lotion, deodorant, perfume, nail polish), air fresheners, synthetic fragrances, and medical tubing. Phthalates are not chemically bound to plastics, meaning they continuously leach out—into your food, your skin, your air. Once inside the body, they act as endocrine disruptors, mimicking and blocking hormones.
In men, they lower testosterone, reduce sperm count, and cause feminization. In women, they disrupt menstrual cycles, trigger early puberty in girls, and contribute to infertility. In children, prenatal phthalate exposure is linked to developmental delays, behavioural issues, and reproductive abnormalities. Phthalates are in your bathroom, your kitchen, your car, and your children’s bedrooms.
They are invisible, omnipresent, and relentless—and they are rewriting human sexual development and hormonal function in real-time.
Heavy Metals: Brain Sabotage
Heavy metals—aluminium, mercury, lead, cadmium, arsenic—are neurotoxins that accumulate in brain tissue, bones, and organs, causing progressive damage that worsens over time. Aluminium is found in antiperspirants, vaccines (as adjuvants), processed foods (baking powder, food additives), cookware, and municipal water supplies treated with aluminium sulphate. Mercury enters the body through dental amalgams (silver fillings), fish consumption (especially tuna, swordfish, and shellfish), vaccines (thimerosal preservative), and industrial pollution. Lead persists in old paint, contaminated water (as seen in Flint, Michigan), pottery glazes, and imported goods. Cadmium comes from cigarette smoke, industrial emissions, and contaminated soil. Arsenic is found in rice, chicken, and contaminated groundwater.
These metals cross the blood-brain barrier, embedding in neural tissue where they trigger oxidative stress, mitochondrial dysfunction, and progressive neurodegeneration. The result: cognitive decline, memory loss, mood disorders, ADHD in children, Alzheimer’s, Parkinson’s, and ALS in adults. Heavy metals do not leave the body naturally. They accumulate over decades, silently destroying neurological function while conventional medicine treats the symptoms and ignores the cause.
Glyphosate: Gut Destroyer
Glyphosate is the active ingredient in Roundup, the world’s most widely used herbicide. It is sprayed on nearly all conventionally grown crops—wheat, oats, corn, soy, canola—and is now found in over 80% of urine samples tested in the U.S. population. Glyphosate was originally patented as an antibiotic, and it functions as one inside your body, systematically destroying beneficial gut bacteria while allowing pathogenic species to thrive. This leads to leaky gut syndrome, autoimmune disease, chronic inflammation, and digestive collapse. Glyphosate also acts as a chelator, binding to essential minerals (magnesium, zinc, manganese, iron) and rendering them unavailable for absorption.
The result is widespread mineral deficiency, which cascades into thyroid dysfunction, bone loss, immune suppression, and impaired detoxification. It has been classified as a probable human carcinogen and is directly linked to non-Hodgkin’s lymphoma. Yet it remains in your bread, your cereal, your oatmeal, and your children’s snacks. Glyphosate is not just killing weeds—it is killing the microbiome, the foundation of human health.
Microplastics: Invisible Invaders
Microplastics are fragments of degraded plastic less than 5mm in size, and nano plastics are even smaller—particles so tiny they pass directly through cell walls. They are everywhere: in the air you breathe, the water you drink, the food you eat, and the dust in your home. Studies have found microplastics in human blood, lungs, liver, kidneys, placenta, and even the brain.
They come from synthetic clothing (releasing fibres in the wash), car tires (abrading on roads), plastic packaging (breaking down over time), personal care products (microbeads in scrubs and toothpaste), and industrial pollution. Once inside the body, microplastics do three things: they physically accumulate in tissue, they leach toxic chemicals (including phthalates, BPA, flame retardants), and they act as vectors for other contaminants, attracting heavy metals, pesticides, and pathogens to their surfaces and transporting them deeper into the body.
Microplastics have been found in newborn babies’ first stool (meconium), meaning babies are now born pre-contaminated. These particles do not biodegrade. They do not leave. They accumulate in every organ, creating inflammatory responses, disrupting cellular function, and introducing a persistent toxic load that the body was never designed to process.
Pathogenic Agents: Trojan Horses of Synthetic Biology
Lipid Nanoparticles
Lipid nanoparticles (LNPs) are synthetic fat bubbles engineered to bypass the body’s natural immune defences and deliver genetic material directly into cells. They were designed for mRNA vaccine technology and are now being used in gene therapies, cancer treatments, and experimental biologics. The problem: LNPs do not stay at the injection site. Studies show they accumulate in the liver, spleen, ovaries, bone marrow, and brain within hours of injection.
Once inside cells, they release their genetic payload—mRNA instructions that hijack the cell’s ribosomes and force them to produce foreign proteins. These proteins trigger immune responses, but the instructions do not stop. The cells continue producing these proteins for weeks, months, or indefinitely. LNPs also contain cationic lipids (positively charged fats) that are inherently toxic, causing inflammation, oxidative stress, and cellular damage.
The long-term effects are unknown because long-term studies were never conducted. What is known: LNPs are accumulating in reproductive organs, crossing the blood-brain barrier, and altering cellular function in ways that cannot be reversed. This is not immunization. This is permanent genetic modification delivered under the guise of medicine.
Hydrogel: Synthetic Scaffold
Hydrogel is a water-absorbing polymer that forms a gel-like matrix inside the body. It is used in drug delivery systems, biosensors, tissue engineering, and increasingly, injectable biologics. Once injected, hydrogel does not dissolve. It expands, forming a synthetic scaffolding within tissue that can house other materials—nanoparticles, sensors, drug reservoirs, and even living cells. Hydrogels are being designed to respond to external stimuli—pH changes, temperature, electromagnetic fields, light—allowing them to release payloads on command. This means the body can be programmed to respond to external signals, turning human tissue into a controllable delivery platform.
Hydrogel is biocompatible in the sense that it does not immediately trigger rejection, but it is not biologically neutral. It creates a permanent foreign structure within the body, altering tissue architecture, interfering with normal cellular communication, and providing a platform for other synthetic systems to anchor and function. The body is no longer purely biological. It is becoming a hybrid environment where synthetic and organic systems coexist—and the synthetic is increasingly in control.
Luciferase
Luciferase is an enzyme that produces bioluminescence—light emitted by living organisms like fireflies and deep-sea creatures. It has been incorporated into vaccine research, gene therapies, and biosensing technologies because it allows researchers to track biological processes in real-time by making cells glow under specific conditions. When luciferase is introduced into human cells (via viral vectors or nanoparticle delivery), those cells produce light when exposed to a substrate (luciferin). This means biological activity inside the body can be monitored externally using imaging technology.
The implications are profound: bodies become readable systems—trackable, measurable, and externally observable. Luciferase is being used to verify vaccine delivery, monitor gene expression, and assess immune responses. But it also means the body is no longer private. Its internal states can be read, recorded, and analysed without consent. This is biological surveillance at the cellular level, and it is being normalized under the banner of medical innovation.
Biological Payloads
Engineered biological payloads include viral vectors (modified viruses), self-replicating RNA, synthetic genes, CRISPR gene-editing tools, and laboratory-designed proteins introduced into the body to alter genetic expression and cellular behaviour. These are not natural pathogens. They are designed organisms created in laboratories to carry out specific tasks: silence genes, activate dormant genetic sequences, introduce new genetic code, or produce foreign proteins indefinitely.
Technologies like self-amplifying mRNA mean that a single injection can produce ongoing effects for months or years because the genetic instructions replicate themselves inside cells. Viral vectors insert DNA directly into the host genome, creating permanent genetic changes that are passed on when cells divide. CRISPR-based gene editing is now being delivered via nanoparticles to rewrite the human genome in vivo—inside living people.
These interventions are being framed as therapies, but they are fundamentally biological reprogramming. The body’s genetic code—once considered sacred, inviolable, the blueprint of individual identity—is now being treated as editable software. And once edited, there is no undo.
Advanced Materials: Alien Level Nanotechnology
Graphene: Conductive Lattice
Graphene is a single layer of carbon atoms arranged in a hexagonal lattice—one atom thick, 200 times stronger than steel, and more conductive than copper. It is being used in electronics, sensors, batteries, and increasingly, biomedical applications. Graphene oxide (GO) has been found in injectable products, masks, swabs, and even water supplies. Once inside the body, graphene does several things: it self-assembles into larger structures, forming networks and sheets. It is electrically conductive, meaning it can interact with the body’s bioelectric systems—nerves, heart, brain. It can cross the blood-brain barrier, accumulating in neural tissue.
It responds to electromagnetic fields, meaning it can be influenced or activated remotely. Studies show graphene causes oxidative stress, inflammatory responses, and cellular toxicity, but it is being introduced anyway—quietly, without disclosure. The body is being transformed into a conductive substrate capable of receiving, transmitting, and processing signals. This is not contamination. This is installation.
Borophene: Neural Interface
Borophene is a two-dimensional material made of boron atoms arranged in a corrugated sheet. It is even more conductive than graphene and exhibits superconductivity under certain conditions. Borophene’s unique properties make it ideal for interfacing with biological systems—particularly neural tissue. It can bond with proteins, integrate into cell membranes, and facilitate direct electrical communication between synthetic materials and living cells.
Research is exploring borophene for brain-computer interfaces, neural implants, and biosensors that monitor brain activity in real-time. The problem: borophene is being introduced into the body through nanoparticle delivery, environmental exposure, and experimental therapies without long-term safety data. Once embedded in neural tissue, borophene forms synthetic-biological junctions—connection points where machine and mind interface directly. This is not enhancement. This is the literal wiring of human consciousness to external systems.
Xenes: Biological Transistors
Xenes are a family of two-dimensional materials analogous to graphene but made from silicon (silicene), germanium (germanene), or tin (stanene). These materials have programmable electronic properties, meaning their conductivity and reactivity can be tuned by external stimuli—voltage, light, electromagnetic fields. This makes them ideal candidates for in-body electronics—biosensors, drug delivery controllers, and implantable circuits that operate inside living tissue. Xenes can function as transistors, switches, and sensors at the nanoscale, forming networks that process information inside the body.
They are being researched for use in “smart” drug delivery systems, where medications are released in response to real-time biological feedback, and in neural interfaces where brain activity can be read and modulated externally. The implication: the body is being transformed into a computational platform, where synthetic materials process biological data and execute programmed responses. Human biology is becoming hybrid biology—part organic, part machine, and increasingly directed by systems outside individual control.
Invasive Systems: Hijacking Human Consciousness
Skull To Voice Technology
Skull-to-voice technology, also known as bone conduction audio or microwave auditory effect, uses electromagnetic frequencies or ultrasound to transmit sound directly into the skull, bypassing the ears entirely.
The sound is perceived as coming from inside the head—like a voice in your thoughts. This technology has been researched by military and intelligence agencies for decades (DARPA, CIA, NSA) and is now being commercialized in consumer devices (bone conduction headphones, hearing aids). But the darker application is remote neural voice transmission—using directed energy to project voices into a target’s head from a distance. Combined with nanotechnology (nanoparticles that respond to electromagnetic fields), this system can deliver auditory messages that feel internal, indistinguishable from one’s own thoughts.
The person believes they are hearing their own inner voice, but the message originates externally. This is not science fiction. Patents exist. Research papers confirm feasibility. And the infrastructure—5G towers, satellites, directed energy systems—is already in place. The question is not whether this technology exists. The question is: how many people are already hearing voices that are not their own?
Optogenetics: Light Control
Optogenetics is a technique that inserts light-sensitive proteins (opsins) into neurons, allowing those neurons to be activated or suppressed using pulses of light. Originally developed for neuroscience research in animals, optogenetics is now being explored for use in humans—to treat blindness, Parkinson’s disease, depression, and chronic pain. The process involves injecting viral vectors carrying opsin genes into the brain. Once integrated, those neurons become light-responsive switches, turning on or off when exposed to specific wavelengths (usually blue or yellow light).
The light can be delivered via fibre optic cables implanted in the brain, or—more concerning—via bioluminescent molecules (like luciferase) that produce light internally when triggered by external signals. This means brain activity can be controlled remotely without physical implants. Mood, memory, decision-making, fear responses, aggression, pleasure—all can be modulated by activating or suppressing specific neural circuits with light. Optogenetics is being framed as a medical breakthrough, but it is fundamentally a neural control system. Once installed, the brain is no longer operating autonomously. It is operating under external influence, and the person may never know.
Sonogenetics: Sound Control
Sonogenetics uses ultrasound waves to activate or inhibit neurons, achieving the same effect as optogenetics but without the need for light or implanted fibres. Mechanosensitive ion channels (proteins that respond to mechanical pressure) are introduced into neurons via viral vectors. Once in place, these neurons become ultrasound-responsive, firing, or shutting down when exposed to focused ultrasound beams. The advantage: ultrasound can penetrate deep into the brain non-invasively, meaning no surgery, no implants, no visible intervention.
Focused ultrasound can target specific brain regions (amygdala, hippocampus, prefrontal cortex) from outside the skull, modulating emotion, memory, impulse control, and executive function remotely. Combined with wearable devices, 5G infrastructure, or satellite-based directed energy, Sonogenetics enables population-scale neural modulation. Mood can be dampened. Aggression can be triggered. Compliance can be enhanced. Resistance can be suppressed. And the person will believe the thoughts and feelings are their own. This is not medical technology. This is weaponized neuroscience.
THE CREATION SOLUTION
Reversing The Invasion
CREATION is the only comprehensive reversal system capable of addressing all four categories of biological invasion simultaneously:The human body was not designed to host synthetic materials, process engineered pathogens, or interface with external control systems. It was designed to self-regulate, self-heal, and remain sovereign. But that design has been systematically compromised.
Detoxifying accumulated toxins (PFAS, phthalates, heavy metals, glyphosate, microplastics) through targeted molecular chelation and elimination pathways
Neutralizing pathogenic agents (lipid nanoparticles, hydrogel, luciferase, synthetic biology) using enzymatic breakdown and immune system reactivation
Dismantling advanced materials (graphene, borophene, xenes) through nano-scale interventions that break synthetic networks and restore natural cellular communication.
Blocking invasive systems (optogenetics, Sonogenetics, electromagnetic manipulation) by restoring the body’s natural frequency (144Hz), rebuilding energetic coherence, and re-establishing biological sovereignty.
This is not detoxification. This is biological reclamation—the systematic removal of foreign code and the restoration of the original human blueprint.
CREATION does not mask symptoms. It removes the cause. It does not manage disease. It restores design.
The question is no longer whether this technology exists or whether you have been exposed. But, will you reclaim your biology, or accept the transformation being done to you without consent?